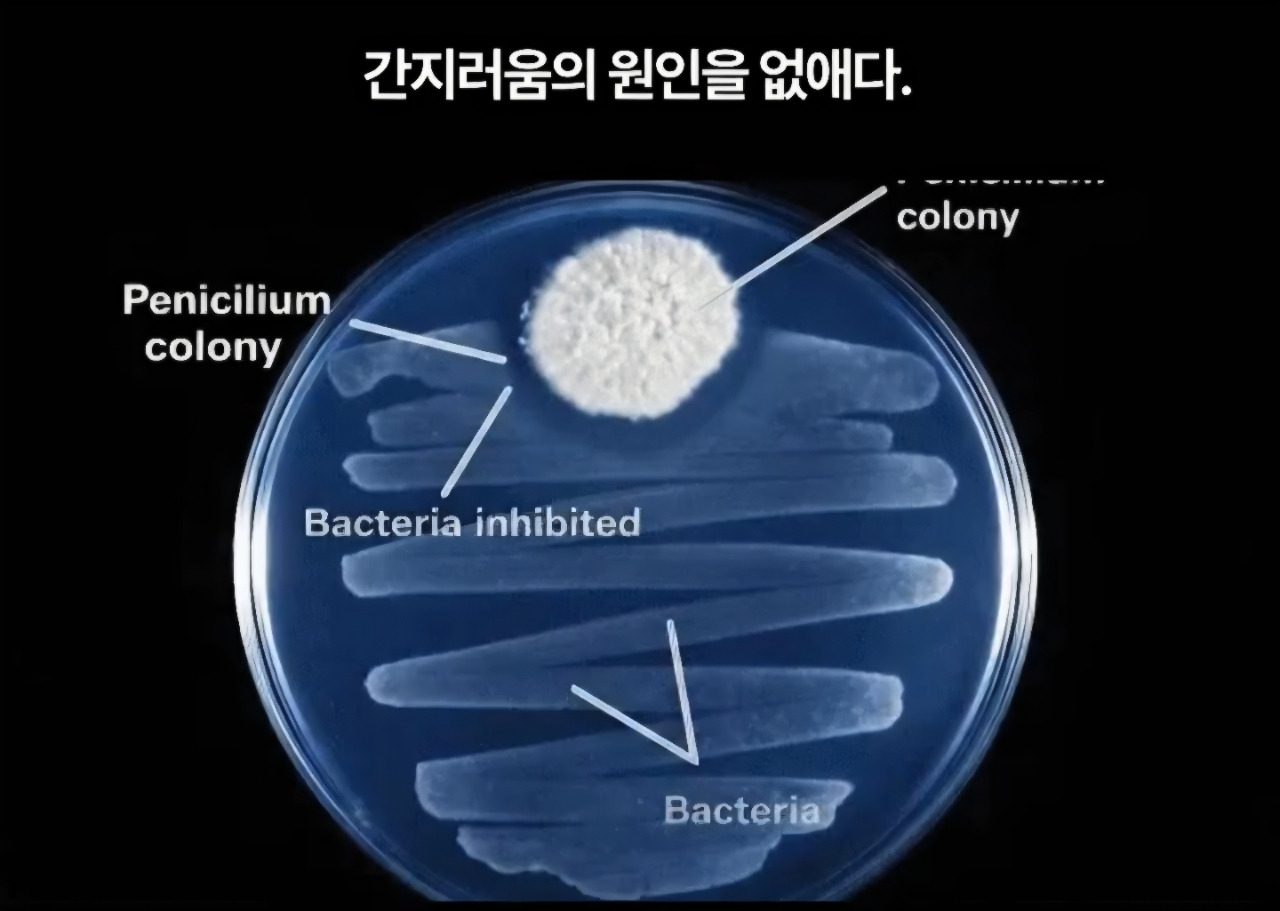

페디실린 풀 케어 솔루션 20ml 1병
이런제품 제안이 정말 수도없이 오는데
효과없는게 대부분입니다.
이제품은 정말좋아 강추드리오니 1병이라도 꼭 사용해 보세요!!^^
세계최초의 항생제 페니실린에서 영감을 받아 간지러움을 과학적으로 없앤 페디실린 풀케어 솔루션은 반복되는 문제성 발톱의 원인인 밀폐,습기, 각질로 인한 균의 재번식을
임상을 통해 오랜기간 연구한 끝에 최대 672시간의 항균력을 개발하여 만든 제품입니다^^
지금까지 고객님들이 사용하신 어떤 발톰케어 제품보다 확실하고 빠른효과가 나올거라고
자부할 수 있습니다!!^^
-10중 히알루론산으로 깊숙하게 작용
-자연에서 유래한 순한 식물성분
-피부 저자극 시험완료
증상을 과장하지 않고 원인을 명확히 짚어 불필요한 단계를 비우고.
쓰임은 분명하고 사용법은 간결하게 하여 매일 사용해도 불편하지 않게 설계했어요
1, 항균&침투 설계
-각질층을 제거하고 층층이 침투하여 오염물질 산균
2. 99.9% 항균력
-문제성 손,발톱을 유발하는 백선균 3종 감소율 99.9% 인증완료
3. 최적의 성분배합
-10중 히알루론산과 판테놀, 알란토인 성분 함유
4. 저자극 시험완료
-피부에 자극적인 성분 대신 자연에서 유래한 순한 식물 성분 함유
단 1회사용으로 적색 백선균99.9% 살균
백색 종창균 99.9% 살균
족선상백선균 99% 살균의 효과가 나타난답니다~
유통기한 28년 8월
최저판매가 1병 8,000원
배송비3,500원 도서산간6,500원

다음검색